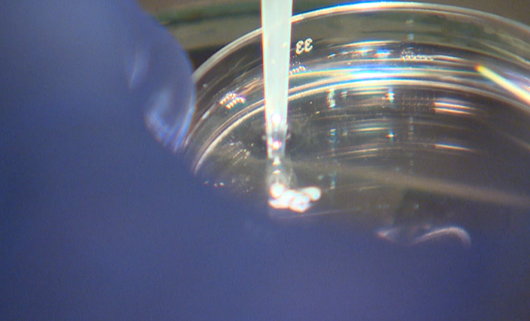

THE OVA WAY
Personalized
We offer truly individualized VIP treatment for women of every age, background and their various reasons for wanting to freeze their eggs.
Results
OVA is in a league of its own as our industry-leading lab brings you the most advanced technologies in cryopreservation, with babies born from eggs frozen in our lab.

A Creation of aParent IVF Laboratory
401 N. Michigan Avenue, Suite 1800, Chicago, IL 60611
info@ovaeggfreezing.com
Media Inquiries: media@ovaeggfreezing.com
312-800-0228
Fax: (312) 253-1441